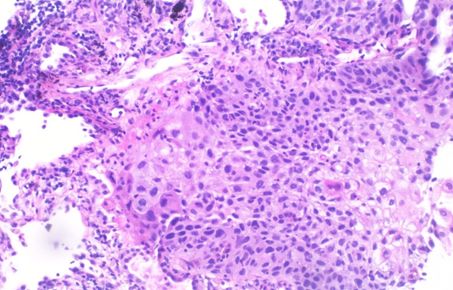

Research themes
Aerosols remain one of the largest uncertainties in our understanding of the most important global grand challenges, including disease transmission (COVID-19), public health, climate change and therapeutics. Multi-disciplinary teams are required to better measure and characterise (physical, chemical and biological) aerosols and their sources, develop processes to synthesise aerosols, to understand toxicological effects, understand and characterise disease transmission, and develop new drugs to the lungs to treat disease.
Research themes

Aerosol technology
Development of aerosol processes that leads to the synthesis of new materials, particle filtrations technologies, and scaling up of lab-scale processes to industrial production.
Prof Jerry Heng (Chemical Engineering, FoE) and Prof Yannis Hardalupas (Mechanical Engineering, FoE)

Aerosol sources and measurement techniques
All aspects related to the sampling and measurement of aerosols and their properties, including concentration, size, shape, composition, the evaluation of the resulting data, and setting of regulatory standards.
Dr David Green (School of Public Health, FoM) and Dr Marc Stettler (Civil and Environmental Engineering, FoE)

Aerosolised inhaled therapeutics and exhaled diagnostics
Development of aerosols that facilitate the delivery of drugs to the lungs, including drug formulations, aerosol design and synthesis, translation from laboratory to applied medicine, and the evaluation of drug effectiveness.
Dr Omar Usmani (NHLI, FoM) and Dr Martyn Biddiscombe (NHLI, FoM)
Research themes 2
Airway biological and toxicological responses
Understanding the relationships between exposure to aerosols and the effects this has on cells and tissues tells us how aerosol particles damage health and how particles might target and relieve disease.
Prof Terry Tetley (NHLI, FoM) and Dr Ian Mudway (School of Public Health, FoM)

Airborne transmission and infectious diseases
Advancing understanding of how aerosols can transmit diseases when pathogens are carried in exhaled droplets and particles, which are then inhaled. This route of transmission is especially important for respiratory diseases, including COVID-19.

Aerosol transport and modelling
Developing fundamental understanding of the processes that control aerosol formation, growth, coagulation, deposition and their interaction with fluid flow from the atomic to continuum scales.
Prof Denis Doorly (Department of Aeronautics, FoE) and Prof Omar Matar (Chemical Engineering, FoE)
